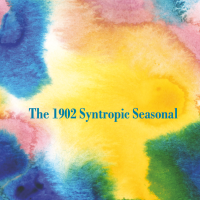
IMG_HOVER_TEXT

027 Syntropic Seasonal

026 Glowing Swords

025 Sub Loam

024 Tape Loop Orchestra

023 Analemma Fault

022 Being / Humble Bee

021 Depatterning

020 The Sly & Unseen

019 offthesky

018 The Laborer

017 Talk West

016 Unoff. Countryside

015 Lost Trail

014 Sashash Ulz

013 offthesky &radere

012 Depatterning

011 Porya Hatami

010 loscil

009 Fescal

008 Depatterning

007 David Newlyn

006 pleq / lüüp

005 offthesky

004 Being

003 Depatterning

002 Depatterning

001 Depatterning
…